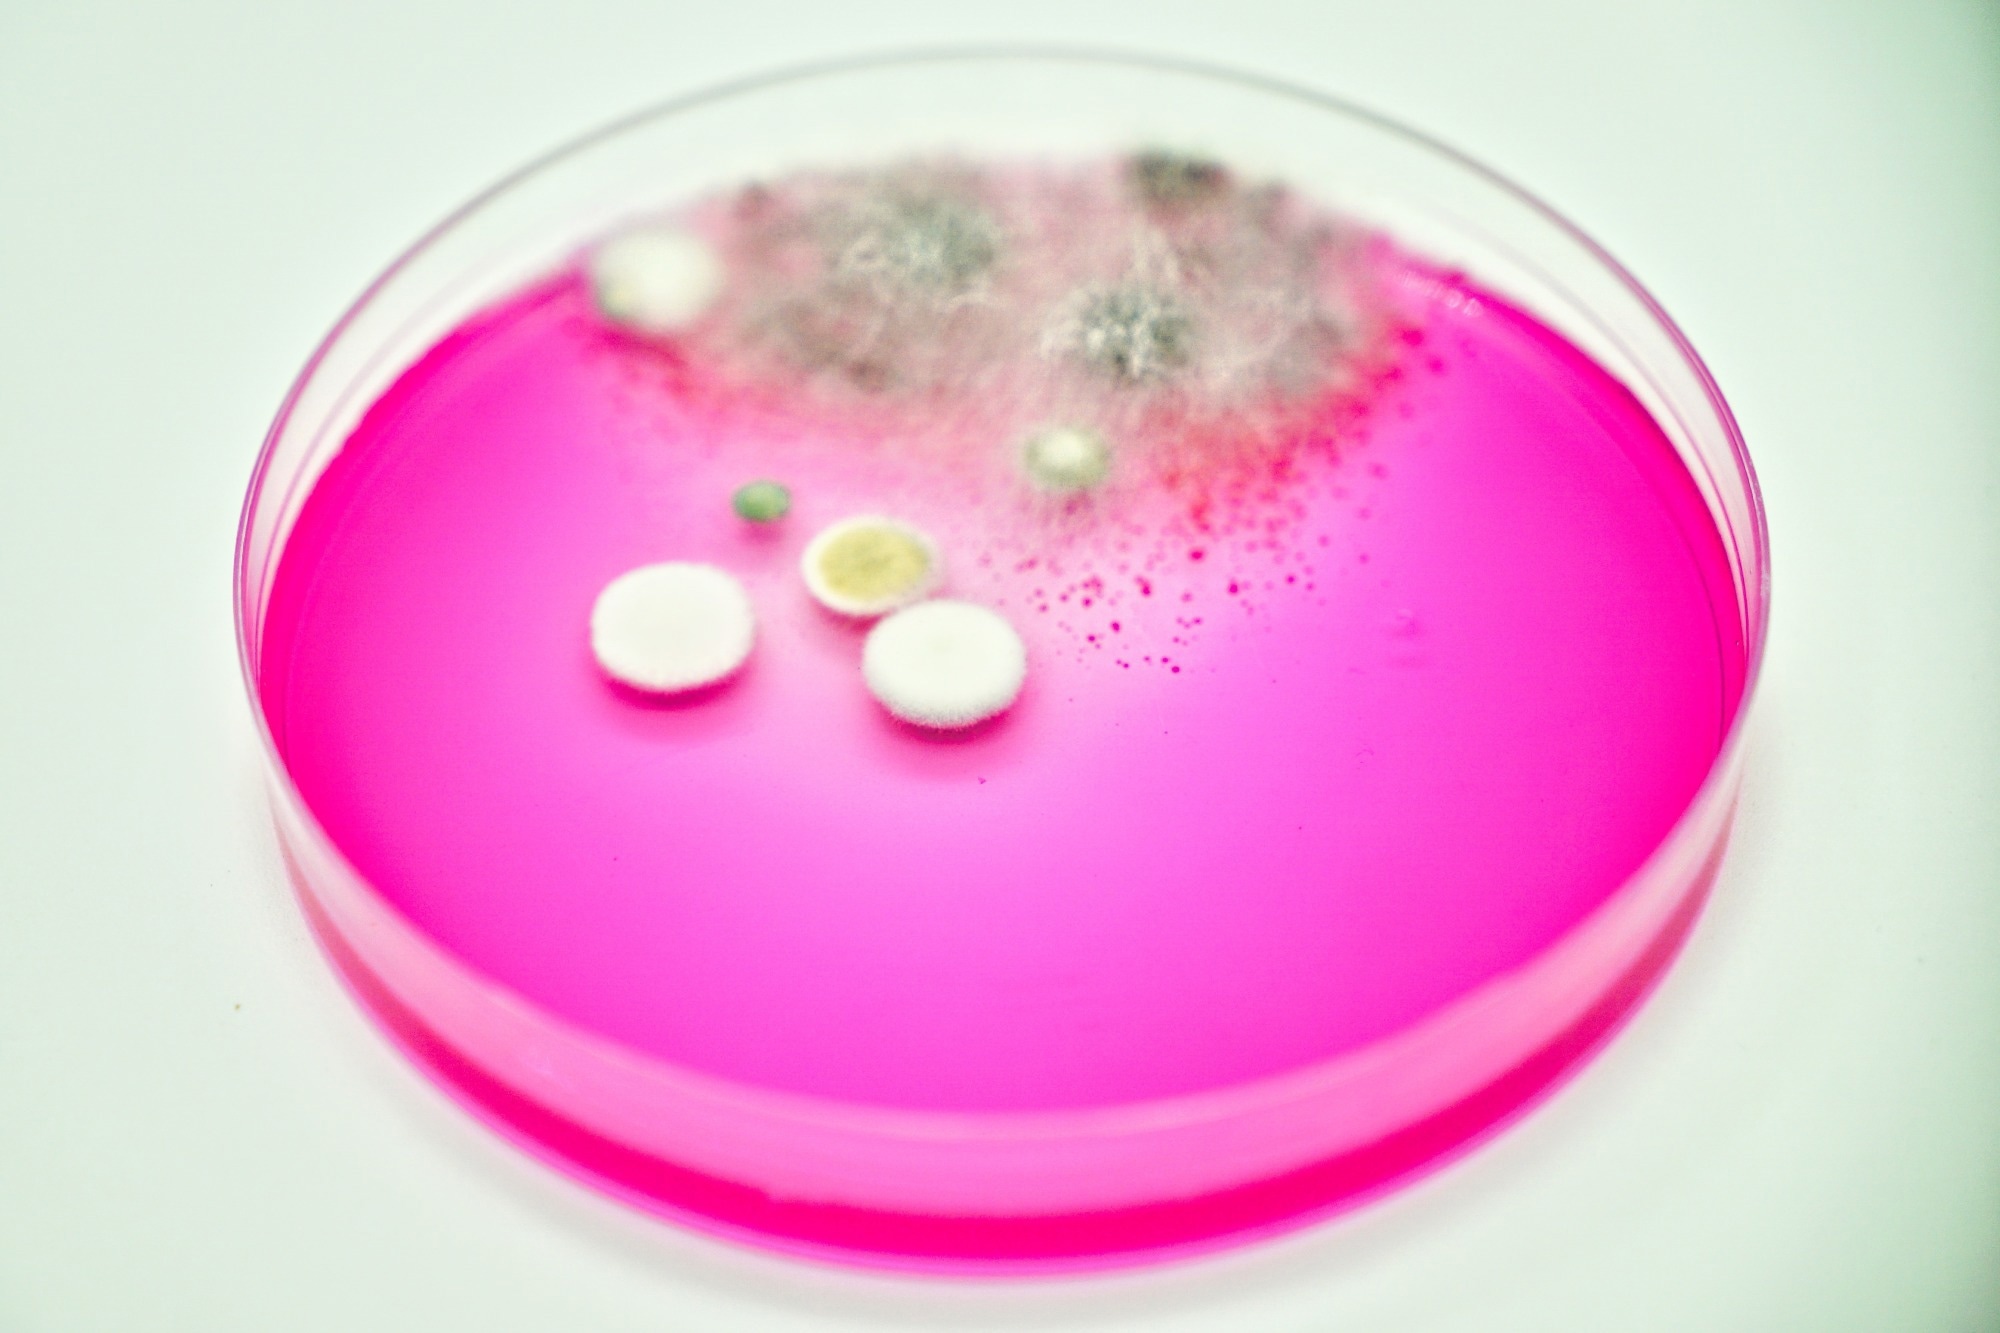
Petri dish with agar and fungi microorganism growth

Certain severe fungal infections are found in specific regions of the United States with unique environmental characteristics and are frequently associated with exposure to contaminated soil. These infections can impact both healthy individuals and those with compromised immune systems; however, the process of accurate diagnosis is often slow, resulting in delayed treatment.
Image credit: Esther Cortez/Shutterstock.com
Image credit: Esther Cortez/Shutterstock.com
The gold standard for diagnosing fungal infections is based on fungal culturing. This process may require several weeks, along with tests that search for antigens, which are not very specific, or antibodies in the bloodstream, which frequently prove unreliable in the early stages of the disease.
Researchers from Indiana University Health and the IU School of Medicine have developed a novel molecular test that can simultaneously identify three significant pathogenic fungi, providing a considerably faster turnaround time compared to conventional methods.
The team aimed to identify three fungal infections that impact thousands of individuals annually, are frequently confused with other respiratory diseases, and pose a significant risk to life, especially for those with compromised immune systems.
Histoplasmosis typically manifests as a lung infection in individuals who have inhaled soil contaminated with the droppings of birds or bats. This condition is most prevalent in the Ohio and Mississippi River valleys. Blastomycosis also manifests as a lung infection, but it can additionally progress to impact the skin, bones, and other organs. This infection is primarily found in the central and southeastern regions of the United States.
Coccidioidomycosis, commonly referred to as Valley fever, is another type of lung infection. While the majority of these infections are mild, some patients may develop severe pneumonia or experience infections in other parts of the body. This condition is mainly found in the southwestern states, including Arizona, California, and New Mexico.
The researchers developed a multiplex real-time PCR test, enabling the simultaneous detection of multiple pathogens from a single sample.
This test focused on three genetic regions specific to each fungus: ITS1 for Histoplasma, BAD1 for Blastomyces, and the A2/PRA gene for Coccidioides. By directly identifying the genetic material of the fungi, the PCR test avoids the lengthy culture process, which is made more complex by the fungi's capacity to transition between environmental and human forms.
When the PCR results were compared to standard laboratory methods, the PCR test successfully identified all tested samples with complete accuracy of 100 %. Furthermore, it demonstrated 100 % specificity, indicating that it did not incorrectly detect other fungi or contaminants.
Additionally, the workflow removes the necessity for lengthy DNA-extraction procedures, which may lead to a decrease in turnaround time and lower the laboratory risks linked to the handling of live pathogenic fungi.
Our assay has the potential to significantly improve turnaround time and diagnostic confidence for infections that have historically been difficult to detect quickly.
Dr. Kenneth Gavina, Ph.D., Director, Clinical Microbiology, Eskanazi Health
Significantly, the system used by the team operates on a platform that is already employed in numerous clinical laboratories, making it potentially very accessible.
While additional clinical validation is under way, this assay shows strong potential to fill a major gap in fungal diagnostics. The assay has the ability to detect the three major causes of endemic mycoses in the United States directly from clinical specimens or be used as a form of definitive identification from fungal culture. Clinicians currently have no FDA-approved molecular tests for these three pathogens, making rapid, reliable detection a pressing need.
Dr. Kenneth Gavina, Ph.D., Director, Clinical Microbiology, Eskanazi Health